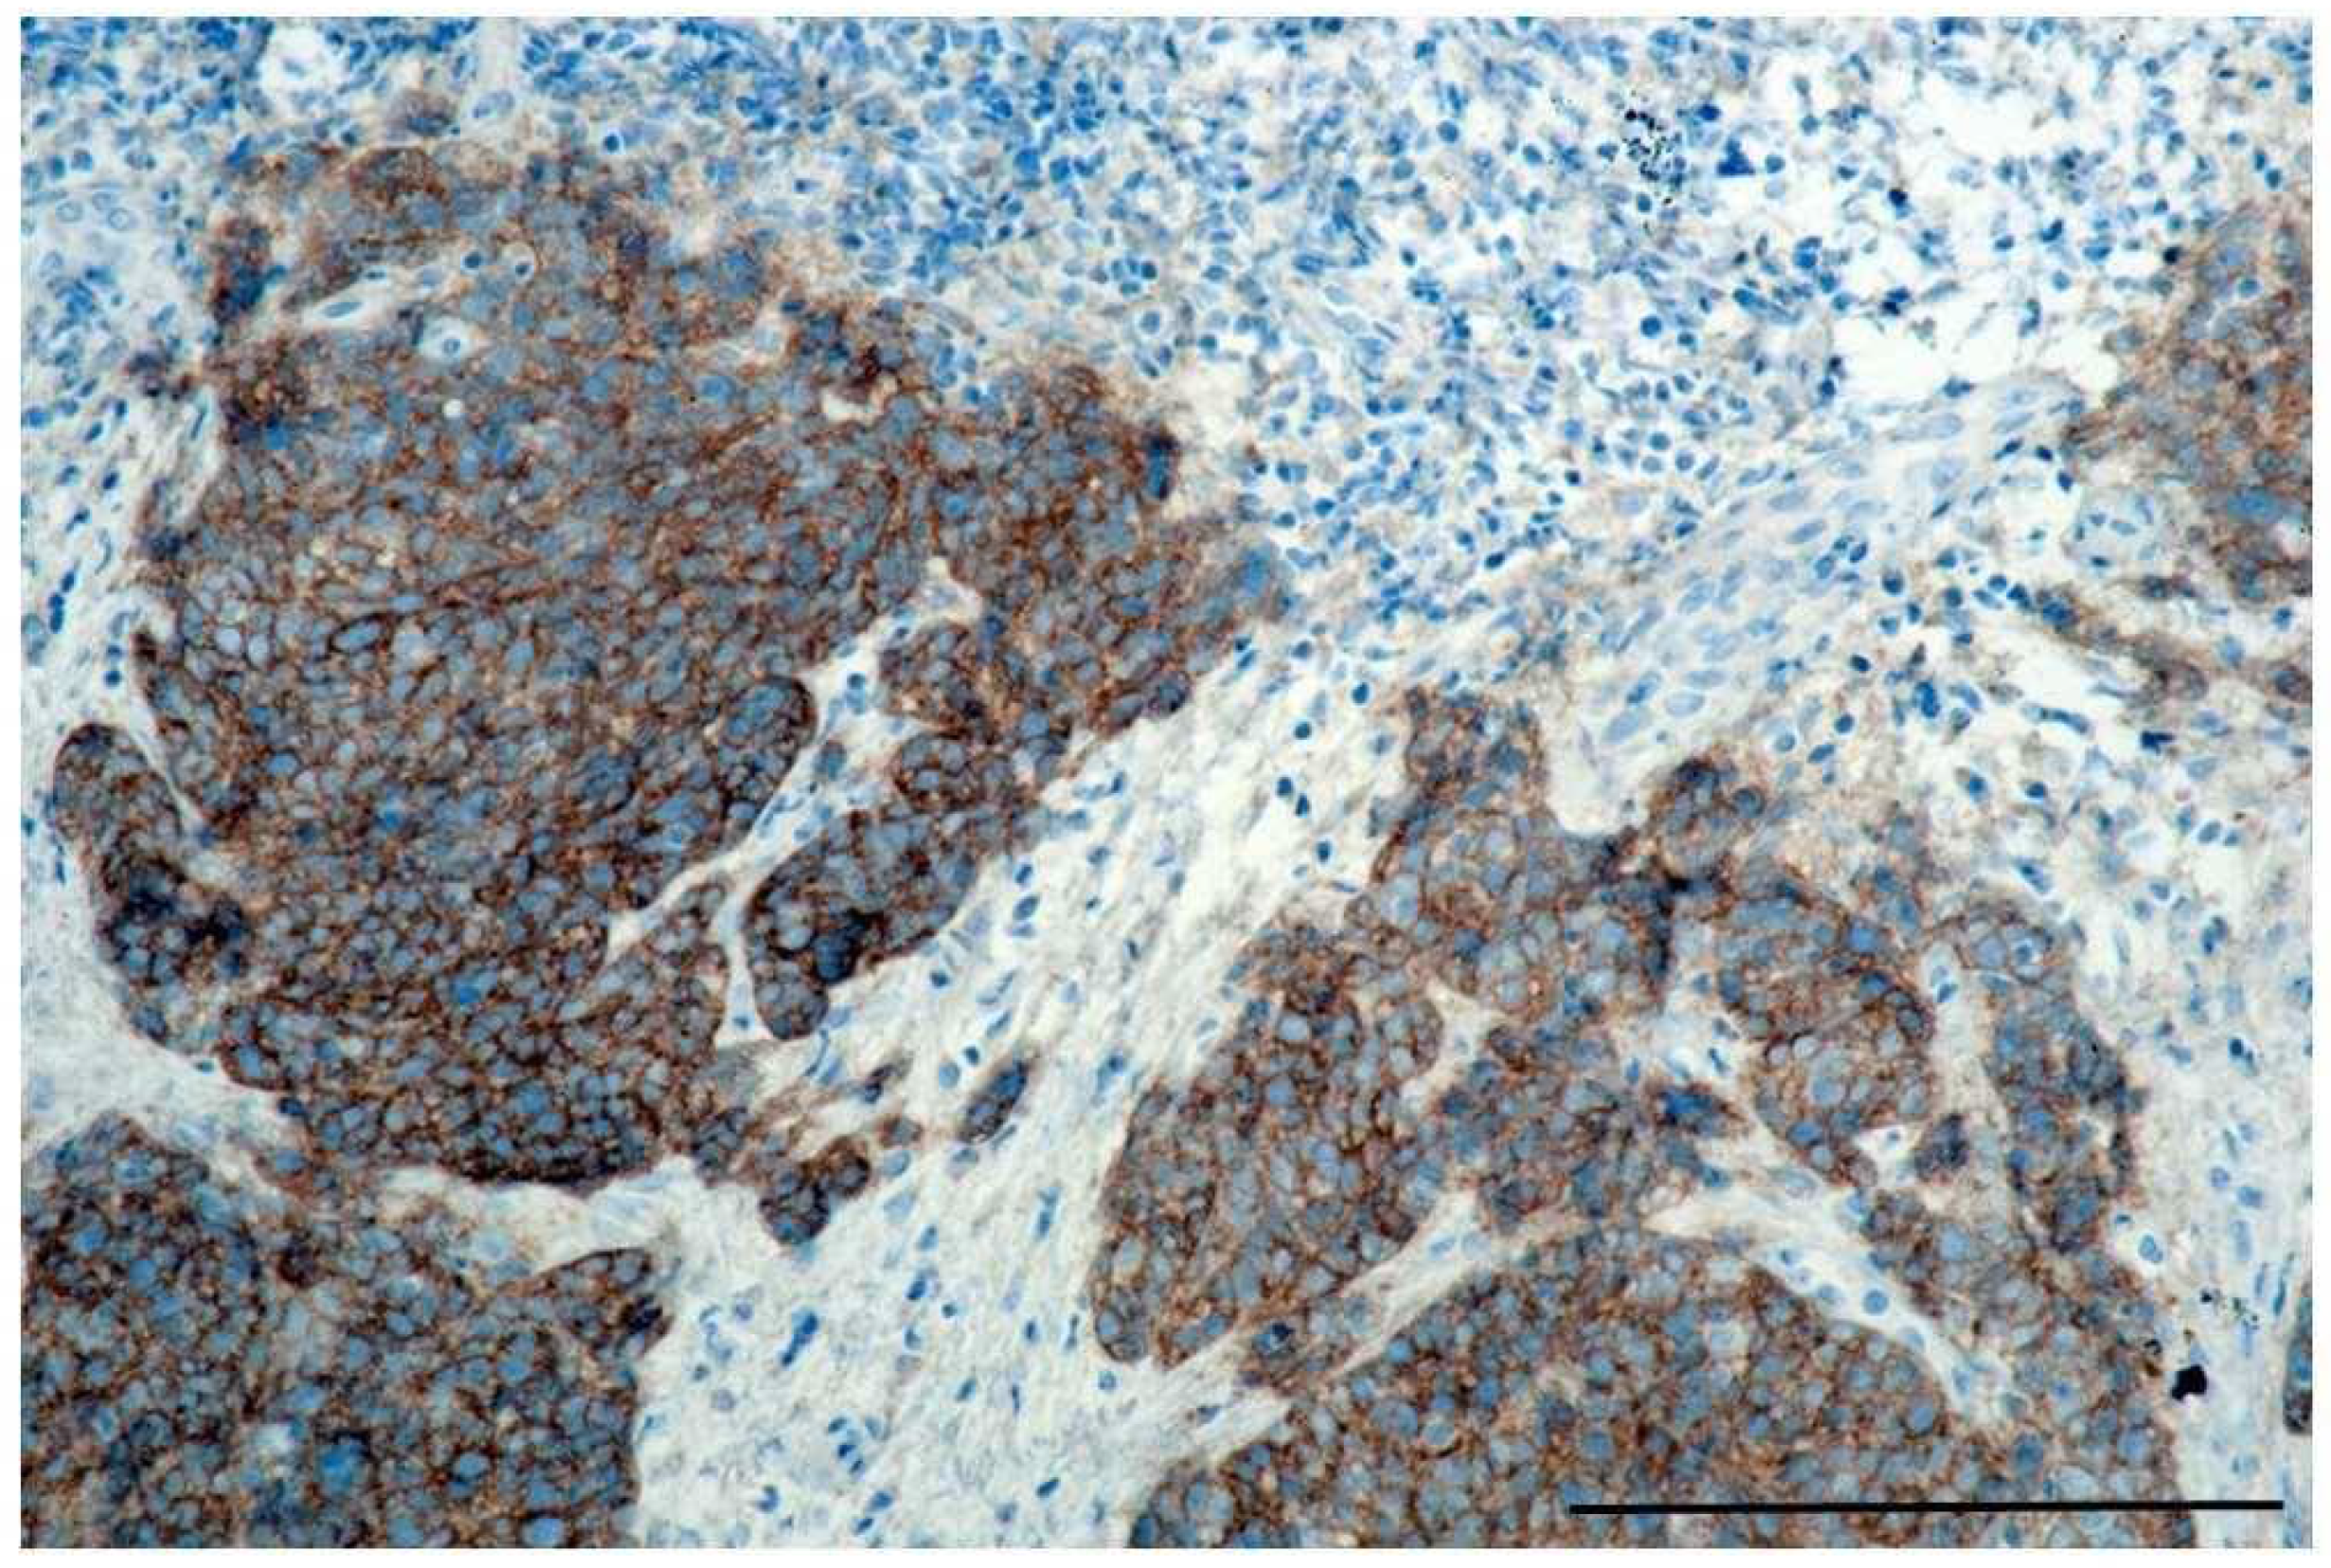

Post-Treatment HPV Surface Brushings and Risk of Relapse in Oropharyngeal Carcinoma
Abstract
1. Introduction
2. Results
2.1. Study Population and Treatment Outcome
2.2. HPV DNA Detection before and after Treatment
2.3. Post-Treatment HPV-Positivity, Recurrent Disease, and Survival
2.4. Factors Associated with Post-Treatment HPV-Positivity
2.5. Post-Treatment HPV-Positivity Virus Persistence or New Infection?
3. Discussion
4. Material and Methods
4.1. Inclusion and Exclusion Criteria
4.2. Specimen Harvest and Handling
4.3. Processing of Brush Specimens
4.4. DNA Amplification and HPV Genotyping
4.5. IHC
4.6. Data Analysis
5. Conclusions
Author Contributions
Funding
Conflicts of Interest
References
- Jung, A.C.; Briolat, J.; Millon, R.; De Reynies, A.; Rickman, D.; Thomas, E.; Abecassis, J.; Clavel, C.; Wasylyk, B. Biological and clinical relevance of transcriptionally active human papillomavirus (HPV) infection in oropharynx squamous cell carcinoma. Int. J. Cancer 2010, 126, 1882–1894. [Google Scholar] [CrossRef]
- Zou, J.; Cao, Z.; Zhang, J.; Chen, T.; Yang, S.; Huang, Y.; Hong, D.; Li, Y.; Chen, X.; Wang, X.; et al. Variants in human papillomavirus receptor and associated genes are associated with type-specific HPV infection and lesion progression of the cervix. Oncotarget 2016, 7, 40135–40147. [Google Scholar] [CrossRef] [PubMed]
- Shanmugasundaram, S.; You, J. Targeting Persistent Human Papillomavirus Infection. Viruses 2017, 9, 229. [Google Scholar] [CrossRef] [PubMed]
- Galloway, D.A.; Laimins, L.A. Human papillomaviruses: Shared and distinct pathways for pathogenesis. Curr. Opin. Virol. 2015, 14, 87–92. [Google Scholar] [CrossRef] [PubMed]
- Ducatman, B.S. The Role of Human Papillomavirus in Oropharyngeal Squamous Cell Carcinoma. Arch. Pathol. Lab. Med. 2018, 142, 715–718. [Google Scholar] [CrossRef] [PubMed]
- Haukioja, A.; Asunta, M.; Soderling, E.; Syrjanen, S. Persistent oral human papillomavirus infection is associated with smoking and elevated salivary immunoglobulin G concentration. J. Clin. Virol. 2014, 61, 101–106. [Google Scholar] [CrossRef]
- Mehanna, H.; Beech, T.; Nicholson, T.; El Hariry, I.; McConkey, C.; Paleri, V.; Roberts, S. Prevalence of human papillomavirus in oropharyngeal and nonoropharyngeal head and neck cancer—Systematic review and meta-analysis of trends by time and region. Head Neck 2013, 35, 747–755. [Google Scholar] [CrossRef]
- Fung, N.; Faraji, F.; Kang, H.; Fakhry, C. The role of human papillomavirus on the prognosis and treatment of oropharyngeal carcinoma. Cancer Metastasis Rev. 2017. [Google Scholar] [CrossRef]
- Zhang, Y.; Waterboer, T.; Haddad, R.I.; Miles, B.A.; Wentz, A.; Gross, N.D.; Fakhry, C.; Quon, H.; Lorch, J.H.; Gourin, C.G.; et al. Human papillomavirus (HPV) 16 antibodies at diagnosis of HPV-related oropharyngeal cancer and antibody trajectories after treatment. Oral. Oncol. 2017, 67, 77–82. [Google Scholar] [CrossRef]
- Hanna, G.J.; Sridharan, V.; Margalit, D.N.; La Follette, S.K.; Chau, N.G.; Rabinowits, G.; Lorch, J.H.; Haddad, R.I.; Tishler, R.B.; Anderson, K.S.; et al. Salivary and serum HPV antibody levels before and after definitive treatment in patients with oropharyngeal squamous cell carcinoma. Cancer Biomark 2017, 19, 129–136. [Google Scholar] [CrossRef]
- Fakhry, C.; Blackford, A.L.; Neuner, G.; Xiao, W.; Jiang, B.; Agrawal, A.; Gillison, M.L. Association of Oral Human Papillomavirus DNA Persistence With Cancer Progression After Primary Treatment for Oral Cavity and Oropharyngeal Squamous Cell Carcinoma. JAMA Oncol. 2019, 5, 985–992. [Google Scholar] [CrossRef] [PubMed]
- Soderlund-Strand, A.; Kjellberg, L.; Dillner, J. Human papillomavirus type-specific persistence and recurrence after treatment for cervical dysplasia. J. Med. Virol. 2014, 86, 634–641. [Google Scholar] [CrossRef] [PubMed]
- Kofler, B.; Borena, W.; Manzl, C.; Dudas, J.; Wegscheider, A.S.; Jansen-Durr, P.; Schartinger, V.; Riechelmann, H. Sensitivity of tumor surface brushings to detect human papilloma virus DNA in head and neck cancer. Oral. Oncol. 2017, 67, 103–108. [Google Scholar] [CrossRef] [PubMed]
- Broglie, M.A.; Jochum, W.; Forbs, D.; Schonegg, R.; Stoeckli, S.J. Brush cytology for the detection of high-risk HPV infection in oropharyngeal squamous cell carcinoma. Cancer Cytopathol. 2015, 123, 732–738. [Google Scholar] [CrossRef]
- Rettig, E.M.; Wentz, A.; Posner, M.R.; Gross, N.D.; Haddad, R.I.; Gillison, M.L.; Fakhry, C.; Quon, H.; Sikora, A.G.; Stott, W.J.; et al. Prognostic Implication of Persistent Human Papillomavirus Type 16 DNA Detection in Oral Rinses for Human Papillomavirus-Related Oropharyngeal Carcinoma. JAMA Oncol. 2015, 1, 907–915. [Google Scholar] [CrossRef]
- Ahn, S.M.; Chan, J.Y.; Zhang, Z.; Wang, H.; Khan, Z.; Bishop, J.A.; Westra, W.; Koch, W.M.; Califano, J.A. Saliva and plasma quantitative polymerase chain reaction-based detection and surveillance of human papillomavirus-related head and neck cancer. JAMA Otolaryngol. Head Neck Surg. 2014, 140, 846–854. [Google Scholar] [CrossRef]
- Song, D.; Kong, W.M.; Zhang, T.Q.; Jiao, S.M.; Chen, J.; Han, C.; Liu, T.T. The negative conversion of high-risk human papillomavirus and its performance in surveillance of cervical cancer after treatment: A retrospective study. Arch. Gynecol. Obstet. 2017, 295, 197–203. [Google Scholar] [CrossRef]
- Verguts, J.; Bronselaer, B.; Donders, G.; Arbyn, M.; Van Eldere, J.; Drijkoningen, M.; Poppe, W. Prediction of recurrence after treatment for high-grade cervical intraepithelial neoplasia: The role of human papillomavirus testing and age at conisation. BJOG 2006, 113, 1303–1307. [Google Scholar] [CrossRef]
- Chatfield-Reed, K.; Gui, S.; O’Neill, W.Q.; Teknos, T.N.; Pan, Q. HPV33+ HNSCC is associated with poor prognosis and has unique genomic and immunologic landscapes. Oral. Oncol. 2020, 100, 104488. [Google Scholar] [CrossRef]
- Fossum, G.H.; Lie, A.K.; Jebsen, P.; Sandlie, L.E.; Mork, J. Human papillomavirus in oropharyngeal squamous cell carcinoma in South-Eastern Norway: Prevalence, genotype, and survival. Eur. Arch. Oto Rhino Laryngol. 2017, 274, 4003–4010. [Google Scholar] [CrossRef]
- Cohen, E.R.; Reis, I.M.; Gomez, C.; Pereira, L.; Freiser, M.E.; Hoosien, G.; Franzmann, E.J. Immunohistochemistry Analysis of CD44, EGFR, and p16 in Oral Cavity and Oropharyngeal Squamous Cell Carcinoma. Otolaryngol. Head Neck Surg. 2017, 157, 239–251. [Google Scholar] [CrossRef] [PubMed]
- Temam, S.; Kawaguchi, H.; El-Naggar, A.K.; Jelinek, J.; Tang, H.; Liu, D.D.; Lang, W.; Issa, J.P.; Lee, J.J.; Mao, L. Epidermal growth factor receptor copy number alterations correlate with poor clinical outcome in patients with head and neck squamous cancer. J. Clin. Oncol. 2007, 25, 2164–2170. [Google Scholar] [CrossRef] [PubMed]
- Chung, C.H.; Ely, K.; McGavran, L.; Varella-Garcia, M.; Parker, J.; Parker, N.; Jarrett, C.; Carter, J.; Murphy, B.A.; Netterville, J.; et al. Increased epidermal growth factor receptor gene copy number is associated with poor prognosis in head and neck squamous cell carcinomas. J. Clin. Oncol. 2006, 24, 4170–4176. [Google Scholar] [CrossRef] [PubMed]
- Sivarajah, S.; Kostiuk, M.; Lindsay, C.; Puttagunta, L.; O’Connell, D.A.; Harris, J.; Seikaly, H.; Biron, V.L. EGFR as a biomarker of smoking status and survival in oropharyngeal squamous cell carcinoma. J. Otolaryngol. Head Neck Surg. 2019, 48, 1. [Google Scholar] [CrossRef] [PubMed]
- Kero, K.; Rautava, J.; Syrjanen, K.; Willberg, J.; Grenman, S.; Syrjanen, S. Smoking increases oral HPV persistence among men: 7-year follow-up study. Eur. J. Clin. Microbiol. Infect. Dis. 2014, 33, 123–133. [Google Scholar] [CrossRef]
- Castillejos-Garcia, I.; Ramirez-Amador, V.A.; Carrillo-Garcia, A.; Garcia-Carranca, A.; Lizano, M.; Anaya-Saavedra, G. Type-specific persistence and clearance rates of HPV genotypes in the oral and oropharyngeal mucosa in an HIV/AIDS cohort. J. Oral. Pathol. Med. 2018, 47, 396–402. [Google Scholar] [CrossRef]
- Rutjes, S.A.; Italiaander, R.; Van den Berg, H.H.; Lodder, W.J.; De Roda Husman, A.M. Isolation and detection of enterovirus RNA from large-volume water samples by using the NucliSens miniMAG system and real-time nucleic acid sequence-based amplification. Appl. Environ. Microbiol. 2005, 71, 3734–3740. [Google Scholar] [CrossRef]
- Tang, Y.W.; Sefers, S.E.; Li, H.; Kohn, D.J.; Procop, G.W. Comparative evaluation of three commercial systems for nucleic acid extraction from urine specimens. J. Clin. Microbiol. 2005, 43, 4830–4833. [Google Scholar] [CrossRef]
- Abreu, A.L.; Souza, R.P.; Gimenes, F.; Consolaro, M.E. A review of methods for detect human Papillomavirus infection. Virol. J. 2012, 9, 262. [Google Scholar] [CrossRef]
- Mason, S.; Gani, A.; Vettorato, M.; Negri, G.; Mian, C.; Brusauro, F. Detection of high-risk HPV genotypes in cervical samples: A comparison study of a novel real time pcr/reverse line blot-based technique and the digene HC2 assay. Pathologica 2012, 6, 104. [Google Scholar]
- Eklund, C.; Forslund, O.; Wallin, K.L.; Dillner, J. Global improvement in genotyping of human papillomavirus DNA: The 2011 HPV LabNet International Proficiency Study. J. Clin. Microbiol. 2014, 52, 449–459. [Google Scholar] [CrossRef] [PubMed]
- Zur Hausen, H.; De Villiers, E.M. Human papillomaviruses. IARC Monogr. Eval. Carcinog. Risks Hum. 2007, 90, 1–636. [Google Scholar]
- Munoz, N.; Castellsague, X.; De Gonzalez, A.B.; Gissmann, L. Chapter 1: HPV in the etiology of human cancer. Vaccine 2006, 24 (Suppl. 3), 1–10. [Google Scholar] [CrossRef] [PubMed]
- Reimers, N.; Kasper, H.U.; Weissenborn, S.J.; Stutzer, H.; Preuss, S.F.; Hoffmann, T.K.; Speel, E.J.; Dienes, H.P.; Pfister, H.J.; Guntinas-Lichius, O.; et al. Combined analysis of HPV-DNA, p16 and EGFR expression to predict prognosis in oropharyngeal cancer. Int. J. Cancer 2007, 120, 1731–1738. [Google Scholar] [CrossRef] [PubMed]
- Bentzen, S.M.; Atasoy, B.M.; Daley, F.M.; Dische, S.; Richman, P.I.; Saunders, M.I.; Trott, K.R.; Wilson, G.D. Epidermal growth factor receptor expression in pretreatment biopsies from head and neck squamous cell carcinoma as a predictive factor for a benefit from accelerated radiation therapy in a randomized controlled trial. J. Clin. Oncol. 2005, 23, 5560–5567. [Google Scholar] [CrossRef] [PubMed]
- Ferris, R.L.; Blumenschein, G., Jr.; Fayette, J.; Guigay, J.; Colevas, A.D.; Licitra, L.; Harrington, K.; Kasper, S.; Vokes, E.E.; Even, C.; et al. Nivolumab for Recurrent Squamous-Cell Carcinoma of the Head and Neck. N. Engl. J. Med. 2016, 375, 1856–1867. [Google Scholar] [CrossRef]
- Mehta, C.R. The exact analysis of contingency tables in medical research. Stat. Methods Med. Res. 1994, 3, 135–156. [Google Scholar] [CrossRef]
- Newcombe, R.G. Improved confidence intervals for the difference between binomial proportions based on paired data. Stat. Med. 1998, 17, 2635–2650. [Google Scholar] [CrossRef]
- Schemper, M.; Smith, T.L. A note on quantifying follow-up in studies of failure time. Control. Clin. Trials 1996, 17, 343–346. [Google Scholar] [CrossRef]

| Variation | Patients (n = 62) |
|---|---|
| Gender | |
| Male | 48 |
| Female | 14 |
| Age during Initial Diagnosis | |
| ≤ 50 | 10 |
| 51–60 | 21 |
| 61–70 | 20 |
| 71–80 | 7 |
| >80 | 4 |
| UICC Stage | |
| stage I | 0 |
| stage II | 5 |
| Stage III | 18 |
| stage IVa | 32 |
| stage IVb | 4 |
| Stage IVc | 2 |
| ASA Score | |
| ASA I/II | 52 |
| ASA III/IV | 9 |
| Therapy | |
| Surgery only | 3 |
| Surgery and PORT | 12 |
| Surgery and RCT/RIT | 5 |
| Primary RCT/RIT | 38 |
| Primary RT | 2 |
| Chemotherapy only | 1 |
| P16 | |
| Negative | 5 |
| Positive | 55 |
| Patient Number | HPV Genotype before Therapy | HPV Genotype after Therapy | Recurrent Tumor/Tumor Progression |
|---|---|---|---|
| 1–50 | single hr-HPV type * | HPV negative | No |
| 51–55 | multiple hr-HPV types ** | HPV negative | No |
| 56–58 | hr-HPV 16 | hr-HPV 16 | Yes |
| 59 | hr-HPV 33 | hr-HPV 33 | Yes |
| 60 | hr-HP 18 | Hr-HPV 18 | Yes |
| 61 | hr-HPV 33 | hr-HPV 16 | No |
| 62 | hr-HPV 18 | hr-HPV 68b | No |
| Patient 1–5 | UICC | Age at Diagnosis | ASA Score | HPV Pre-Treatment | Therapy | HPV Post-Treatment | Course of Disease |
|---|---|---|---|---|---|---|---|
| Patient 1 | Stage III | 55 | 2 | HPV 16 | RCT | HPV 16 | Recurrence |
| Patient 2 | Stage I | 54 | 2 | HPV 16 | Surgery and PORT | HPV 16 | Pulmonal metastasis Locoregional control |
| Patient 3 | Stage III | 73 | 3 | HPV 16 | RCT | HPV 16 | Recurrence |
| Patient 4 | Stage IV | 86 | 2 | HPV 33 | CT only | HPV 33 | Tumor progression |
| Patient 5 | Stage III | 70 | 2 | HPV 18 | RCT | HPV 18 | Recurrence after partial response |
© 2020 by the authors. Licensee MDPI, Basel, Switzerland. This article is an open access article distributed under the terms and conditions of the Creative Commons Attribution (CC BY) license (http://creativecommons.org/licenses/by/4.0/).
Share and Cite
Kofler, B.; Borena, W.; Dudas, J.; Innerhofer, V.; Dejaco, D.; Steinbichler, T.B.; Widmann, G.; von Laer, D.; Riechelmann, H. Post-Treatment HPV Surface Brushings and Risk of Relapse in Oropharyngeal Carcinoma. Cancers 2020, 12, 1069. https://doi.org/10.3390/cancers12051069
Kofler B, Borena W, Dudas J, Innerhofer V, Dejaco D, Steinbichler TB, Widmann G, von Laer D, Riechelmann H. Post-Treatment HPV Surface Brushings and Risk of Relapse in Oropharyngeal Carcinoma. Cancers. 2020; 12(5):1069. https://doi.org/10.3390/cancers12051069
Chicago/Turabian StyleKofler, Barbara, Wegene Borena, Jozsef Dudas, Veronika Innerhofer, Daniel Dejaco, Teresa B Steinbichler, Gerlig Widmann, Dorothee von Laer, and Herbert Riechelmann. 2020. "Post-Treatment HPV Surface Brushings and Risk of Relapse in Oropharyngeal Carcinoma" Cancers 12, no. 5: 1069. https://doi.org/10.3390/cancers12051069
APA StyleKofler, B., Borena, W., Dudas, J., Innerhofer, V., Dejaco, D., Steinbichler, T. B., Widmann, G., von Laer, D., & Riechelmann, H. (2020). Post-Treatment HPV Surface Brushings and Risk of Relapse in Oropharyngeal Carcinoma. Cancers, 12(5), 1069. https://doi.org/10.3390/cancers12051069

